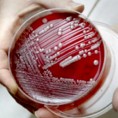
Отпорне бактерије вребају болеснике

Здравље
недеља, 27. дец 2009, 10:18 -> 10:35
Дефектан ген један од узрока астме
Амерички стручњаци идентификовали су ген који у дефектном стању може да доведе до развоја астме код деце. Ово откриће отвара научницима врата ка разоткривању тајни које обавијају алергијска обољења...
субота, 26. дец 2009, 12:27 -> 13:00
На корак од пилуле за контролу уноса алкохола
Европски стручњаци започели су испитивање лека којим би могло да се смањи жеља за алкохолом. У 80 здравствених центара широм континента пратиће се учинак препарата, али могућа нежељена дејства...
субота, 26. дец 2009, 07:44 -> 07:57
Кување у друштву ублажава стрес
Уколико желите да одагнате нежељене мисли и ублажите свакодневни стрес, кувајте у друштву. Стручњаци саветују да помаже и ако се припремање хране не посматра као обавеза и рутина, већ као прилика за забаву...
субота, 26. дец 2009, 07:37 -> 07:56
Отпорне бактерије вребају болеснике
Здравље пацијената који бораве у америчким болницама све више угрожавају бактерије отпорне на лекове. Према резултатима најновијег истраживања, број инфекција изазваних тим бактеријама утростручен је...
петак, 25. дец 2009, 07:34 -> 08:13
У шустера најгоре ципеле
Упркос очекивањима кувари, који знају све о томе како да припреме укусно и здраво јело, имају најнездравије животне навике. На врху листе нашли су се захваљујући пушењу и тамањењу грицкалица и чоколаде...
четвртак, 24. дец 2009, 13:15 -> 21:12
Матичнe ћелијe „оправиле“ рожњачу
Пацијенту којем је рожњача била оштећена амонијаком лекари су третманом матичним ћелијама повратили вид. Уз помоћ ткива постељице, из здравог ока пренете су матичне ћелије, које су потом регенерисале рожњачу...
среда, 23. дец 2009, 07:44 -> 08:08
Зелени чај штити од депресије
Истраживање јапанских научника показало је да је зелени чај, поред многих благотворних дејстава, добар и за превенцију депресије. Кључ је у амино киселини теанину који подстиче добро расположење...
уторак, 22. дец 2009, 12:24 -> 12:47
Раном дијагнозом до боље терапије
Број оболелих од аутизма и сличних можданих поремећаја расте свуда у свету. За аутизам нема лека, а лекари верују да нове дијагностичке методе могу да помогну у раном лечењу...
уторак, 22. дец 2009, 07:37 -> 07:45
Природни протеин блокира вирус Х1Н1
Протеин IFITM3, кога природно лучи људски организам, блокира умножавање вируса новог грипа, открили су амерички научници. Тај протеин могао би да буде кључ за развој нових антивирусних лекова, али тек...
понедељак, 21. дец 2009, 07:37 -> 12:05
Заштитно дејство пробиотика
Свакодневном употребом млечних производа обогаћених пробиотицима може се побољшати опште здравствено стање и способност организма да се супротстави болестима, тврде руски стручњаци...

Коментари